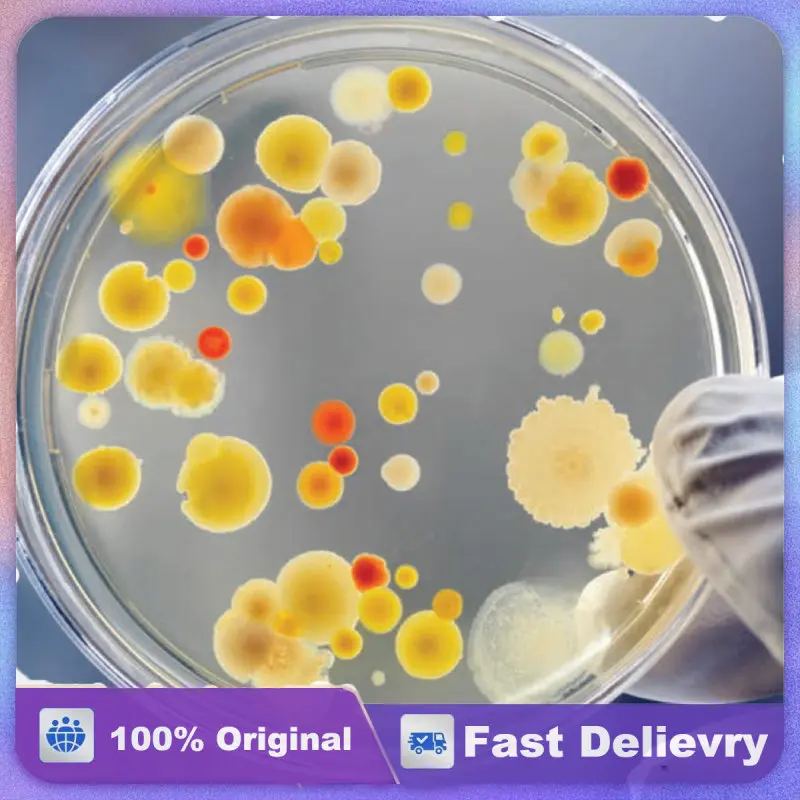

Бальное платье с открытыми плечами, платья Quinceanera для вечерние Ринок, модные платья из органзы с аппликацией для 16 принцесс, платья на день р...














артикул: 1005004857657664
СОГЛАСНО НАШИМ ДАННЫМ, ЭТОТ ПРОДУКТ СЕЙЧАС НЕ ДОСТУПЕН
$89.60
Доставка из: Китай
График изменения цены & курс обмена валют
Пользователи также просматривали

$78.10
New!Car Indicator Headlamp Headlight Switch Knob Wiper Switch Switchgroup Wire For Mitsubishi Pajero V31 V32 Montero MK2 1990-19
aliexpress.com
$110.05
6 Panels Heavy Duty Dog Puppy Playpen Foldable Exercise Puppy Kennel Cage Heavy Duty Dog Cage for Dog Cat Rabbit Pet Exercise
aliexpress.com
$9.46
Hip Hop Portals Melanie Martinez T Shirt Men's Cotton Short Sleeve Music Round Neck Summer Tops
aliexpress.com
$4.26
2PCS Universal Mini Motorcycle Turn Signal Flashers Plastic Refitting Accessories Easy Installation For Suzuki Honda
aliexpress.com
$19.20
4600mAh High Capacity Mobile Phone Battery For onyx book Carta/Poke Pro Digital Smartphon Batteries
aliexpress.com
$25.50
Matte Black Dual Slat Kidney Car Front Grille For-BMW E36 92-96 Grill 51138122237, 51138122238 325Is 325I 318I 318Is
aliexpress.com
$81.39
For Bentley Continental Flying Spur 2005-2013 Headlight Chrome Ring 3W5807763,3W5807768,4W0807834A, 4W0807824A
aliexpress.com
$13.83
New Summer Baby Girls Clothes Suit Children Boys Cartoon Shirt Shorts 2Pcs/Sets Toddler Fashion Casual Costume Kids Sportswear
aliexpress.com
$29.15
NEW Top One Turbo Solenoid Boost Valve For BMW Land Rover Vauxhall Opel OEM STC4198 11742246175 2246175 EGR147
aliexpress.com
$17.50
2022 Men's Loose Toyota Print Logo Running Sports Pullover Autumn Sweatshirt For Men High Street Solid Color Hoodie
aliexpress.com
$5.88
Three-dimensional Chiffon Spring Summer Small Lace Cute Small flowers DIY Handmade Clothing Accessories 6cm Decorative flowers
aliexpress.com
$58.86
2021 new women sweater with hat 100% pure wool knitting female pullovers 7colors special process knit jumpers long sleeve clothes hezh, White;black
dhgate.com
$70.92
gym red 9 men shoes 9s jumpman bred dream it do it racer blue anthracite black white statue mens trainers sports sneakers
dhgate.com
$40.41
Estar Bluetooth and Fitness Tracker Smartwatch TipTop Air Compatible Smartwatch(Brown Strap Regular)
flipkart.com
$17.49
ASDS-Women's Off Shoulder Top Ruffle Long Sleeve Chiffon Blouse Casual Loose Shirts
aliexpress.com
$7.41
Island Hoppers Magnum PI Lunch Bags Insulated Bento Box Leakproof Lunch Tote Picnic Bags Cooler Thermal Bag for Woman Children
aliexpress.com
$238.79
ATK RS7 Rainbow IP eSports Hall Effect Клавиатура с ЧПУ Алюминиевый верхний чехол для игр
aliexpress.ru
$12.28
1 двустороннее фланелевое одеяло на тему врача, диван с 3D цифровой печатью, одеяло для комнаты с кондиционером
aliexpress.ru